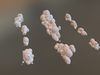
thumbnail

3D Features
Textures
The model includes image files (textures) that add color, patterns, or detail to its surfaces.
Materials
The model has material settings that define how surfaces look (color, shine, transparency, etc.).
UV Mapping
The model's surfaces are mapped to a 2D image, allowing textures to display correctly.
Plugins Used
Some external plugins were used to create the model. These may be required for full functionality.
3D printing
Indicates whether the designer marked this model as suitable for 3D printing.
Model is not 3D printable
The designer indicates this model is intended for digital use only (rendering, animation, or AR/VR) and not for 3D printing.
Geometry
Polygon mesh
A model built from polygons (triangles or quads) connected in a mesh.
10354 polygons
The total number of polygons (flat shapes) that make up the 3D model.
/ 5541 verticesThe number of points (corners) that define the shape of the model's polygons.
Unwrapped UVs
Non-overlapping
Publish date
2021-07-29
Model ID
#3180717